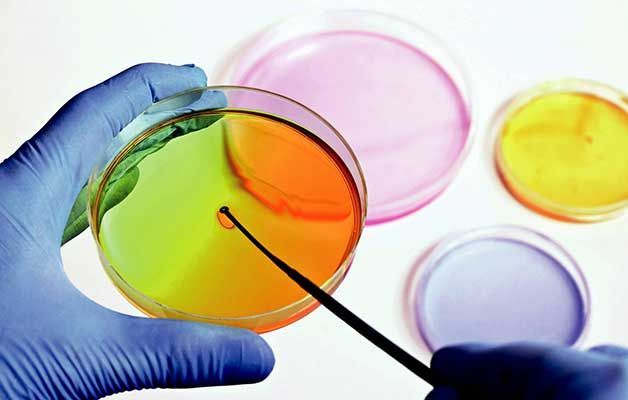
Una persona sostiene una placa de Petri con una aguja dentro.

Contamos con estudios de electrocardiogramas o electrocardiografía, el cual es un estudio que revisa y muestra que tan lento o rápido late tu corazón, auxiliar para diagnóstico clínico y médico de las Arritmias, que son ritmos cardíacos irregulares, procedimiento rápido e indoloro.
°- ELECTROCARDIOGRAMA ECG
°- ESTUDIOS DE ELECTROCARDIOGRAMA EKG.